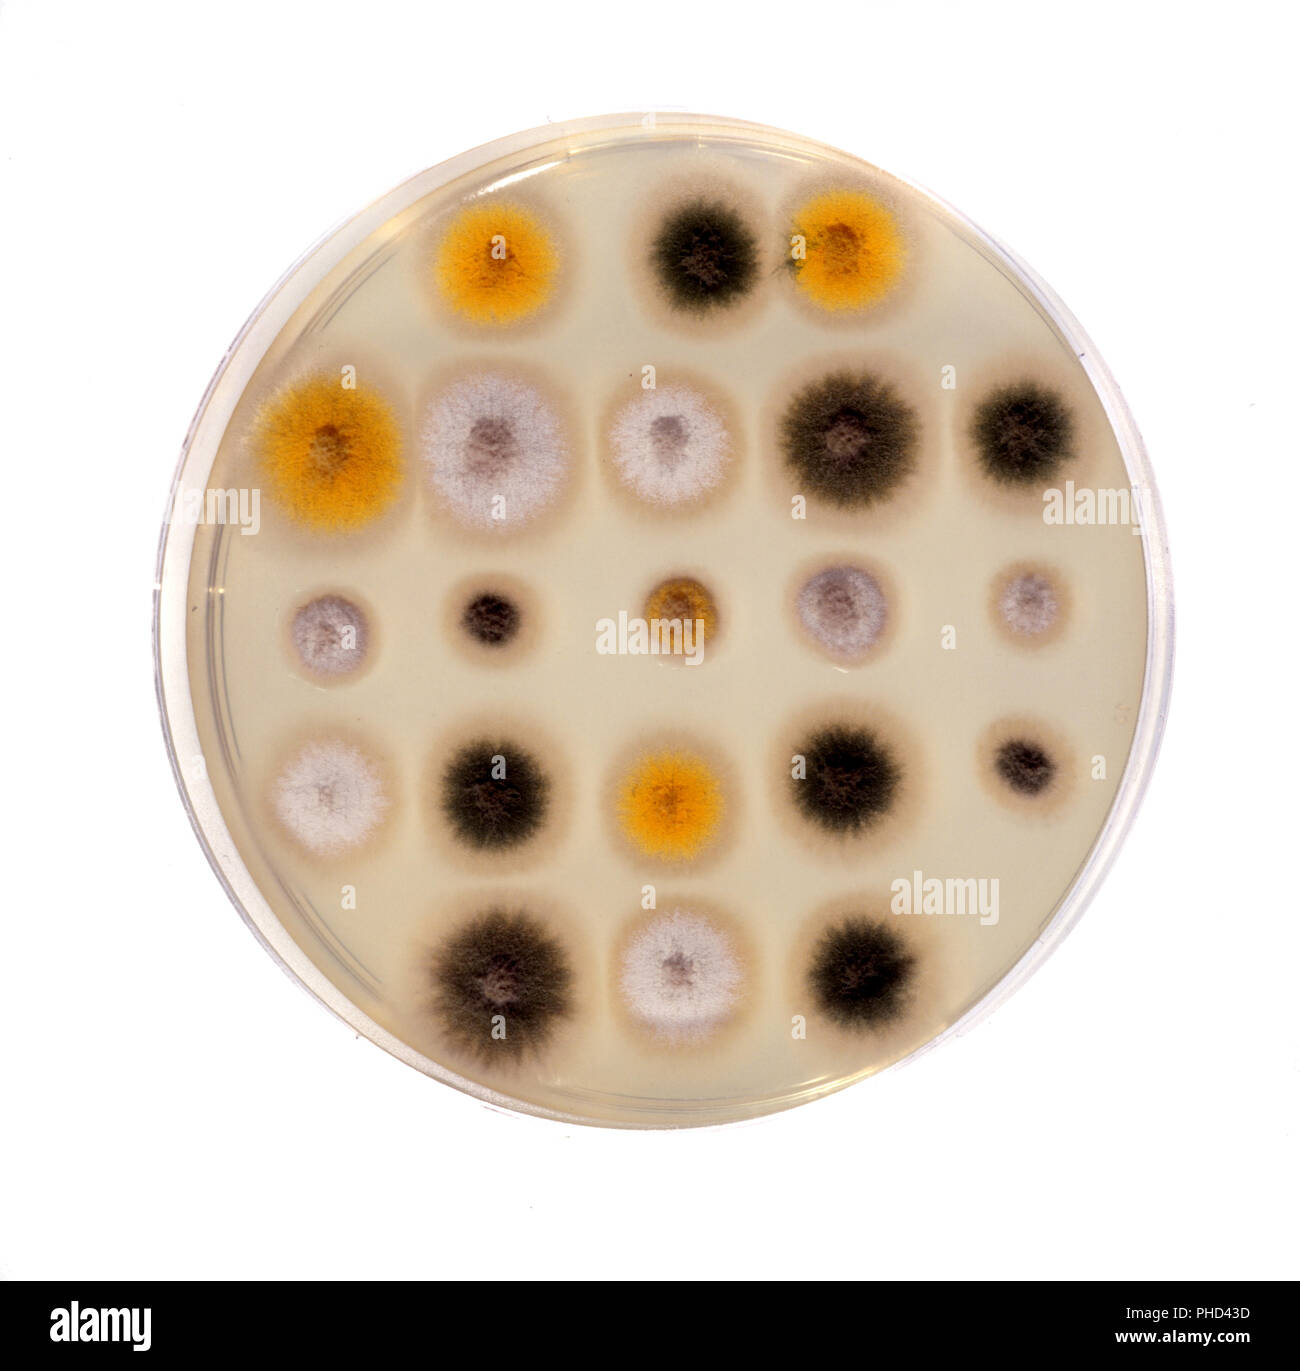
Wissenschaft, die sich mit der biologischen Test im Labor Stockfoto
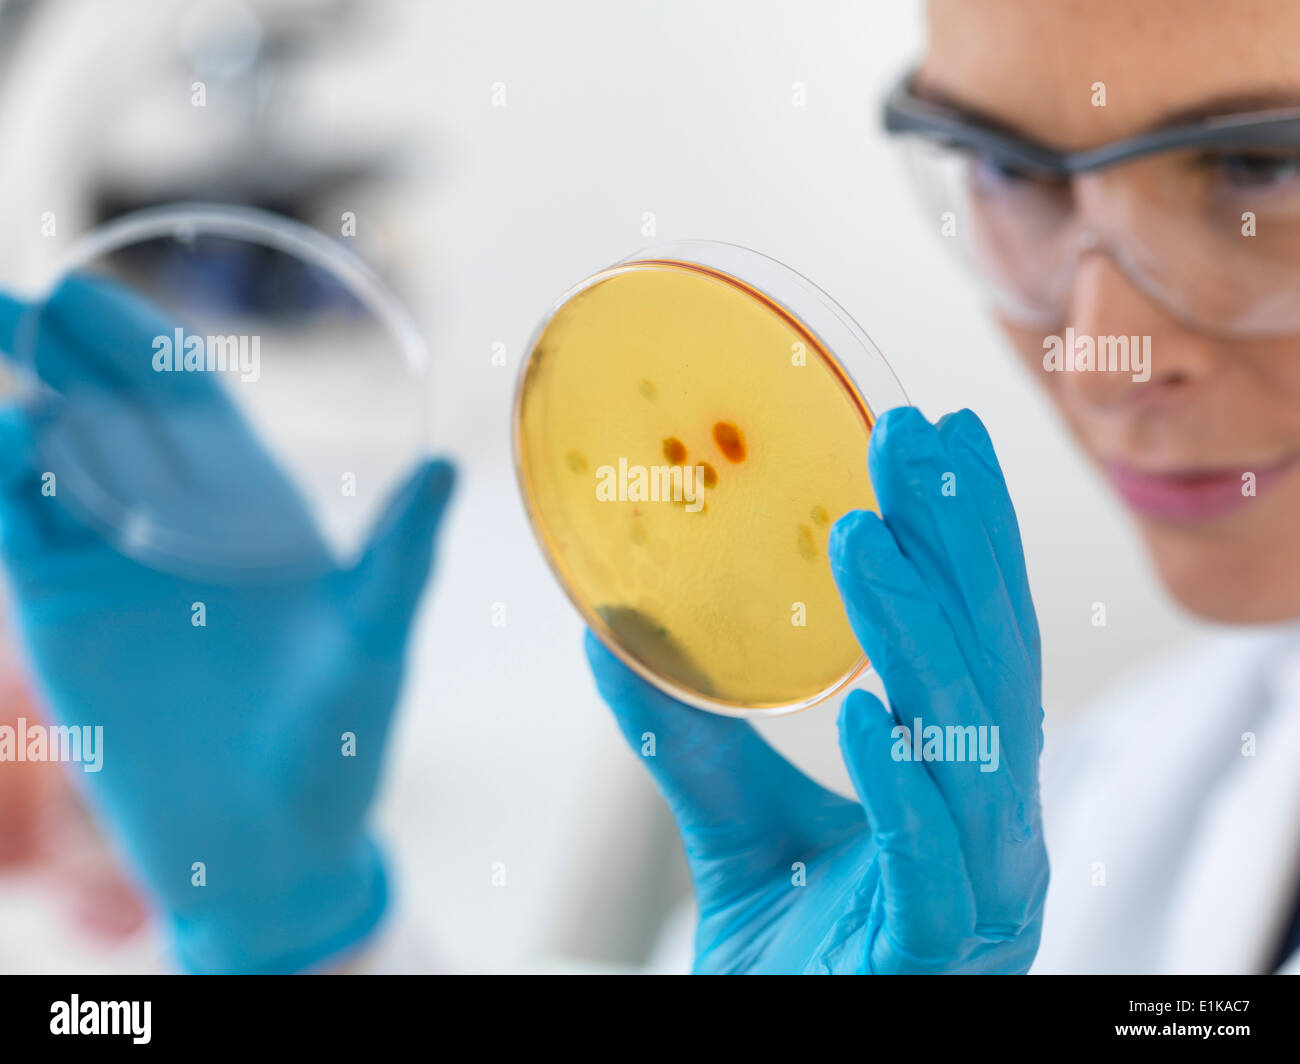
Die Wissenschaftlerin hält Petrischale mit biologischen Kulturen. Stockfoto

Schnellfilter:
Biologische entdeckung Stockfotos & Bilder

RMFRPDWF–Biologie, Biotechnologie, chemische, biologische, Chemiker, heilen, entdecken, Entdeckung, Arzt, Experiment, experimentell, Experti

RFHX39NH–Genetischen Durchbruch und medizinische Gen Therapie Behandlungskonzept Entdeckung als ein Dart, ein Ziel zu treffen, durch das brechen einer Doppelhelix.

RF2S85PBW–Touristen auf Bootsfahrt durch die Mangroven gesäumte Flussmündung des Flusses Nosara und das biologische Reservat bei Sonnenuntergang, Boca Nosara, Nosara, Guanacaste, Costa Rica

RF2X9HE5R–Die Hand eines Wissenschaftlers liegt in der Nähe von Reagenzgläsern in einem Labor, mit Kopierraum

RF2G5J14E–Biologe Forscher Wissenschaftler betrachten Blattprobe unter einem medizinischen Mikroskop, während sie biologische Expertise auf Notizblock schreiben. Chemiker untersucht biologische Entdeckungen im Labor für Mikrobiologie.

RFH824MM–Weibliche forensische Techniker sammeln von biologischen Proben in DNA-Röhre, Nahaufnahme von Womans Hände in weißer uniform mit gesampelten co

RM2D6AJ8A–Geschichte, Wissen, Untersuchung, Vergangenheit, Ereignisse, Gedächtnis, Entdeckung, Historiker,

RFP9WERJ–Biologische Entdeckung. Smart schön stattlich Wissenschaftler ein Reagenzglas und es in seine Arbeit einbezogen werden

RF2F53CF2–Verbundmikroskope oder biologische Mikroskope, die in Labors, Schulen, Kläranlagen, Tierarztpraxen und für Histologie und PA verwendet werden

RMFRPDTF–Biologie, Biotechnologie, chemische, biologische, Chemiker, heilen, entdecken, Entdeckung, Arzt, Experiment, experimentell, Experti

RFG88Y7A–Stem Cell Dna oder Stammzellen Genetik-Konzept als eine drei dimensionale Darstellung von biologischen Zellen dieser Kluft durch Mitose findet man bei Menschen mit einem Doppel-Helix-Strang mit Chromosomen Schwellenländern als eine medizinische Wissenschaft Gesundheitsforschung Symbol als 3D-Artist

RME4MDE9–Paul A. Nelson, Ph.D., Mitglied des Discovery Institute, vor einem Publikum in Atlanta, Georgia, USA.

RF2G3DRN5–Biologe Forscher Wissenschaftler betrachten Blattprobe unter einem medizinischen Mikroskop, während sie biologische Expertise auf Notizblock schreiben. Chemiker untersucht biologische Entdeckungen im Labor für Mikrobiologie.

RFH824NG–Weibliche forensische Techniker sammeln von biologischen Proben in DNA-Röhre, Nahaufnahme von Womans Hände in weißer uniform mit gesampelten co

RF2MBWYK2–Geologin mit einer Lupe untersucht die Natur und analysiert Steine oder Kiesel. Forscher sammeln Proben von biologischen Materialien. Umweltschützer

RMFRPDX3–Biologie, Biotechnologie, chemische, biologische, Chemiker, heilen, entdecken, Entdeckung, Arzt, Experiment, experimentell, Experti

RF2HNGP7E–Luftverschmutzung und DNA-Konzept als Flugzeug mit Rauch in Form eines doppelten Spiralstrang mit 3D Illustrationselementen.

RME4MD7X–Paul A. Nelson, Ph.D., Mitglied des Discovery Institute, vor einem Publikum in Atlanta, Georgia, USA.

RF2G8BJ04–Biologe Wissenschaftler, der mit einem medizinischen Mikroskop die Blattprobe anschaut und gleichzeitig GVO-Expertise auf Notizblock schreibt. Chemiker untersucht biologische Entdeckung auf Pflanzen arbeiten in pharmazeutischen Labor.

RFH824MP–Weibliche forensische Techniker sammeln von biologischen Proben in DNA-Röhre, Nahaufnahme von Womans Hände in weißer uniform mit gesampelten co

RF2MBWYN4–Geologin mit einer Lupe untersucht die Natur und analysiert Steine oder Kiesel. Forscher sammeln Proben von biologischen Materialien. Umweltschützer

RF2CY2AMG–Mikroskop auf dem Tisch im Labor. Linie von Mikroskopen auf Tischen in einem Krankenhauslabor ohne Menschen.

RMFRPDTP–Biologie, Biotechnologie, chemische, biologische, Chemiker, heilen, entdecken, Entdeckung, Arzt, Experiment, experimentell, Experti

RF2G22C12–Biologe Splecialist nimmt mit Pinzette Grünblatt Probe unter dem Mikroskop Analyse genetischer Mutation. Chemiker untersucht biologische Entdeckung auf Pflanzen arbeiten in pharmazeutischen Labor.

RF2JPCG93–Ray - Ei, ist ein organisches Gefäß, das von einem Tier angebaut wird, um eine möglicherweise befruchtete Eizelle (eine Zygote) zu tragen und daraus einen Embryo innerhalb der EG zu bebrüten

RF2TCC09E–Wissenschaft, Chemie, Technik, Biologie und Menschen mit Reagenzglasforschung im klinischen Labor

RF2MBWYJM–Geologin mit Mobiltelefon, um Bilder zu machen, die Natur zu untersuchen und Steine oder Kiesel zu analysieren. Forscher sammeln Proben von biologischen Materialien

RFD9P326–Vogelperspektive von vier Personen in einem Chemielabor Experimente, Analyse von Substanzen auf einem Labortisch und schreiben auf ein bla

RF2CY2AW8–Mikroskop auf dem Tisch im Labor. Linie von Mikroskopen auf Tischen in einem Krankenhauslabor ohne Menschen.

RF2J07F6B–Mikrobiologe hält mit Schutzhandschuhen biologische Impfstoffröhrchen auf Laborhintergrund. Hinter der wissenschaftlichen Entdeckung. Gesundheitswesen und medi

RMFRPDWD–Biologie, Biotechnologie, chemische, biologische, Chemiker, heilen, entdecken, Entdeckung, Arzt, Experiment, experimentell, Experti

RFRGMT00–Heilung für Krebs und medizinische Forschung mit Hilfe von Biotechnik und neuen pharmazeutischen DNA Engineering als genetische Immuntherapie Behandlung.

RFKKNG70–Arbeiten mit biologischen Stoffen im Labor. Hand mit Pinzette Nahaufnahme. Konzept: Biologische Forschung

RF2G22AB3–Biologe Wissenschaftler, der mit einem medizinischen Mikroskop die Blattprobe anschaut und gleichzeitig GVO-Expertise auf Notizblock schreibt. Chemiker untersucht biologische Entdeckung auf Pflanzen arbeiten in pharmazeutischen Labor.

RMJ3CMF7–Dieser Titel bezieht sich auf eine wissenschaftliche oder literarische Klassifikation, die wahrscheinlich mit einer Arbeit oder Entdeckung auf dem Gebiet der Biologie, Astronomie oder klassischen Studien zusammenhängt. Die spezifische Referenz könnte eine bestimmte Art, einen Stern oder ein bestimmtes Konzept betreffen.

RM2WJM6AM–Der Vordereingang des Museums hat ein großes Mosaik, Fliesen Wandgemälde mit einem Evolutionsthema. Im Biologischen Museum auf dem Campus von Al-Farabi Kasachisch N

RM2CC1MN0–Das Francis Crick Institute, ein biomedizinisches Forschungszentrum in London, wurde 2010 gegründet und 2016 in Midland Road, London, Großbritannien, eröffnet

RF2MBWYPC–Weibliche Geologin, die mit dem Mobiltelefon Daten aufzeichnet und dabei Steine oder Kies analysiert. Forscher sammeln Proben von biologischen Materialien. Umwelt und e

RFD9P363–allgemeine Ansicht von Studenten in einem Chemielabor, Experimente unter der Aufsicht von zwei Erzieherinnen und einer Tafel mit f

RF2J07M58–Nahaufnahme des Laborraums mit biologischen Röhrchen und Mikroskop auf weißem Hintergrund. Hinter der wissenschaftlichen Entdeckung. Gesundheitswesen und Medizin

RMFRPDX2–Biologie, Biotechnologie, chemische, biologische, Chemiker, heilen, entdecken, Entdeckung, Arzt, Experiment, experimentell, Experti

RFE7EK0M–Zukunft der Medizin und Biotechnologie-Konzept als eine magische Pille Kapsel mit Getriebe und Zahnräder im Inneren als medizinische Symbol für Nano-Roboter-Technologie biologische Krankheit zu heilen und menschliche Lebensdauer durch innovative Wissenschaft verlängern.